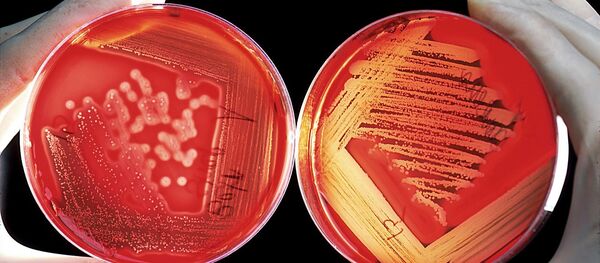
تجارب علمية - سبوتنيك عربي

وأصبح من السهل في السنوات الأخيرة، فبركة خطاب لسياسي أو فيديو لأحد المشاهير، بمزج صور وأصوات بطريقة محترفة، لتبدو حقيقية تماما، ومن الصعب تمييزها، ما جعل خبراء التكنولوجيا يطلقون عليها "Deep Fakes" (التزييف العميق)، ولكن أصبح للفئران دور فعال في الكشف عنها وبسهولة، بحسب موقع "سي نت دوت كوم" التكنولوجي.
ويعمل باحثون من جامعة أوريغون، حاليا، على تدريب الفئران على تمييز الاختلالات في الكلام، وهي مهمة يمكن لهذه الحيوانات أداؤها بدقة كبيرة، أملا منهم في أن بحثهم هذا قد يسهم في النهاية في مساعدة مواقع من أمثال "فيسبوك" و"يوتيوب" لتحديد المقاطع المفبركة بطريقة "التزييف العميق" قبل أن تنتشر على منصاتهما.
Overcoming "deep fake" videos with mice?? A research team at the University of Oregon’s Institute of Neuroscience is working on training mice to understand irregularities within speech, a task the animals can do with remarkable accuracy. https://t.co/1VG3CVWgpj pic.twitter.com/yB0Waeg9rH
— Cybera (@cybera) August 12, 2019
ويقول جونثان سوندرز، من معهد علوم الأعصاب بجامعة أوريغون: "على الرغم من اعتقادي أن فكرة غرفة ممتلئة بالفئران تميز المقاطع الصوتية المفبركة على يوتيوب في اللحظة تبدو بديعة حقا، لكنني لا أعتقد أن ذلك سيكون عمليا لأسباب واضحة".
ويوضح "ساندرز": "علمنا الفئران أن تخبرنا عن الفرق بين صوتي "باه" و"غاه" في سياقات مختلفة، وعندما يكونان مُحاطين بمختلف أصوات العلة، لذا باتت الفئران تعرف التمييز بين أصوات "بوه" بيه" وباه" وكل تلك الفروقات الدقيقة التي لا ندقق نحن فيها ونأخذها كمسلمات".
وتابع: "لأن الفئران يمكنها فعليا تعلم المشكلة المعقدة لتصنيف مختلف أصوات الكلام، نعتقد أنه من الممكن تدريبها على تمييز الكلام المزيف من الحقيقي، وقد نجحت الفئران في تحقيق ذلك بنسبة 80% من زمن التجربة".
ولعل من أشهر نماذج "التزييف العميق"، المقطع المفبرك لمؤسس شركة "فيسبوك" للتواصل الاجتماعي، مارك زوكربيرغ، الذي يتحدث فيه علنا عن سرقة بيانات المستخدمين لموقعه.
ويؤكد فريق البحث العلمي من جامعة أوريغون، أن الهدف النهائي من بحثهم، "ليس تدريب جيشا من الفئران للتمييز بين الأخبار المزيفة العميقة والصحيحة، ولكن مراقبة نشاط أدمغة الفئران، وقدراتهم الخاصة التي يكشفون بها الكلمات المزيفة، ومن ثم تطبيق هذه الطريقة عبر الكومبيوتر".